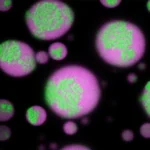

PS em Lisboa pede apuramento de responsabilidades para restaurar a confiança pública

“A gravidade desta tragédia coloca sobre o presente momento uma responsabilidade pública institucional sem precedentes. Estamos diante da tragédia do século, o que exige da Câmara Municipal de Lisboa uma atuação firme, transparente e diligente. É evidente que há um antes e um depois deste acidente, e o futuro da confiança pública depende da forma como serão apuradas as causas e assumidas as responsabilidades pelo município,” declarou o vereador do PS, Pedro Anastácio.
O PS na Câmara de Lisboa defendeu que o acidente com o elevador da Glória exige do município “uma atuação firme, transparente e diligente”, desde o apoio às vítimas até o apuramento de responsabilidades, para restaurar a confiança pública.
“A gravidade desta tragédia coloca sobre o presente momento uma responsabilidade pública institucional sem precedentes. Estamos diante da tragédia do século, o que exige da Câmara Municipal de Lisboa uma atuação firme, transparente e diligente, percebendo-se bem que há um antes e um depois deste acidente e que o futuro da confiança pública depende da forma como forem apuradas as causas e assumidas as responsabilidades pelo município,” afirmou o vereador do PS Pedro Anastácio, em declarações à agência Lusa.
O descarrilamento do elevador da Glória ocorreu na quarta-feira à tarde e resultou em 16 mortes e mais de 20 feridos, de várias nacionalidades.
Nos primeiros momentos que se seguiram ao acidente, a vereação do PS optou por “alguma contenção” nas declarações, “dada a gravidade do evento”, e agora se pronuncia com a apresentação de medidas para responder à tragédia de forma “rápida e transparente”, como a criação de um gabinete municipal de apoio às vítimas, que oferecerá apoio psicológico, assistência jurídica, coordenação com o Ministério dos Negócios Estrangeiros e ajuda para despesas imediatas.
“A criação de um memorial na Calçada da Glória” é outra das propostas do PS, que também se centra no apuramento de responsabilidades sobre o acidente. O partido solicita à empresa municipal Carris, responsável pela gestão do elevador, que disponibilize “no prazo de 24 horas” todos os contratos associados a este equipamento, incluindo o ajuste direto para garantir a prestação de serviços de manutenção.
O PS propõe ainda a formação de uma comissão externa de auditoria que inclua universidades para “avaliar o cumprimento das obrigações contratuais, fiscalização dos serviços prestados e padrões de manutenção dos ascensores e funiculares de Lisboa.”
A proposta do PS será apresentada em uma reunião extraordinária da câmara, agendada para segunda-feira, cujo único ponto de discussão será o acidente com o elevador da Glória.
Essa reunião extraordinária foi anunciada na quinta-feira pelo presidente da Câmara de Lisboa, Carlos Moedas (PSD), após sua participação em uma reunião do Conselho de Ministros, a convite do primeiro-ministro, Luís Montenegro (PSD), realizada no Palácio de São Bento.
Para o vereador Pedro Anastácio, essa reunião deveria ter ocorrido antes: “Fazia sentido que Carlos Moedas tivesse começado por aí e não por São Bento, uma vez que o presidente da câmara coordena a resposta a partir do município.”
Quanto às responsabilidades políticas a serem assumidas em relação a este acidente, o socialista evitou fazer pedidos de demissão, enfatizando a importância do apuramento das causas do descarrilamento. No entanto, lembrou que a responsabilidade última recai sobre o presidente da câmara, uma vez que a Carris é uma empresa municipal.
“É o município que estabelece e direciona a política da Carris. Ele é o sócio único, por isso, no âmbito das responsabilidades técnicas e políticas, elas devem ser assumidas nesse contexto,” declarou o vereador do PS, indicando que cabe a Carlos Moedas fazer essa avaliação.
“Há a pergunta do que é que o Carlos Moedas 2021 tem a dizer ao Carlos Moedas 2025,” ressaltou Anastácio, lembrando a posição do social-democrata durante a campanha eleitoral de 2021, quando pediu a demissão do então presidente da câmara, Fernando Medina (PS), devido à partilha de dados de ativistas russos pela prefeitura.
O vereador do PS expressou “incredulidade e indignação” ao ouvir a declaração de quinta-feira do presidente da Carris, Pedro de Brito Bogas, considerando que ele pareceu buscar uma demonstração de que tudo foi feito corretamente.
“Parece uma conclusão precipitada e que causa um sentimento de revolta,” destacou, sugerindo que o presidente da Carris esclareça a situação em uma reunião de câmara marcada para 11 de setembro.
Sobre a externalização da manutenção dos elevadores da Carris, incluindo o da Glória, o socialista afirmou que a questão “não é apenas se a manutenção é interna ou externa, mas se é adequadamente realizada, se é bem feita e se oferece segurança e confiança a quem utiliza a rede.”